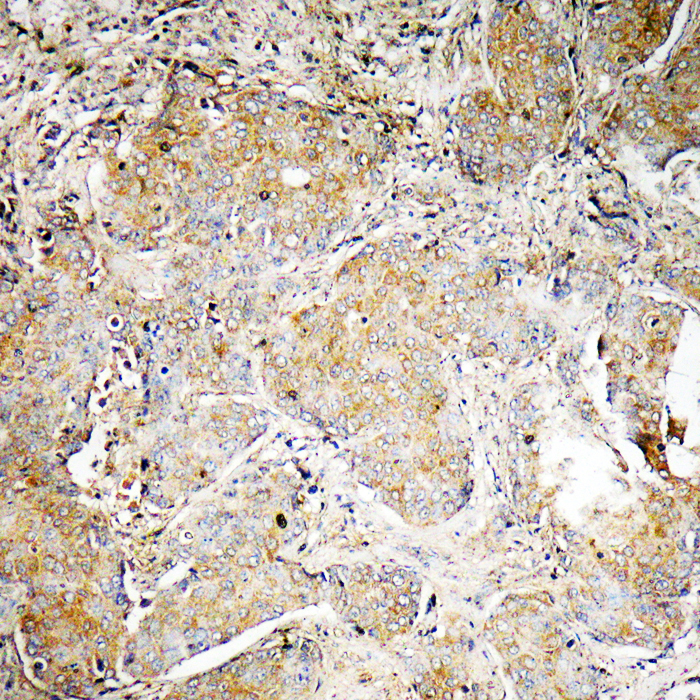

-
分类: 科研抗体货号: P43647别名: OA1; G-protein coupled receptor 143; Ocular albinism type 1 protein应用: WB反应种属: Human,Mouse,Rat
-
分类: 科研抗体货号: P43615别名: NTF2; Nuclear transport factor 2; NTF-2; Placental protein 15; PP15应用: WB,IHC反应种属: Human,Mouse,Rat
-
分类: 科研抗体货号: P43630别名: KIAA1655; Thyrotroph embryonic factor应用: WB,IHC反应种属: Human,Mouse,Rat
-
分类: 科研抗体货号: P43646别名: TGR5; G-protein coupled bile acid receptor 1; G-protein coupled receptor GPCR19; hGPCR19; Membrane-type receptor for bile acids; M-BAR; hBG37; BG37应用: WB反应种属: Human,Mouse,Rat
-
分类: 科研抗体货号: P43614别名: NT5C3; P5N1; UMPH1; Cytosolic 5'-nucleotidase 3A; Cytosolic 5'-nucleotidase 3; Cytosolic 5'-nucleotidase III; cN-III; Pyrimidine 5'-nucleotidase 1; P5'N-1; P5N-1; PN-I; Uridine 5'-monophosphate hydrolase 1; p36应用: WB,IHC,IF反应种属: Human,Mouse
-
分类: 科研抗体货号: P43629别名: FACT140; FACTP140; FACT complex subunit SPT16; Chromatin-specific transcription elongation factor 140 kDa subunit; FACT 140 kDa subunit; FACTp140; Facilitates chromatin transcription complex subunit SPT16; hSPT16应用: WB,IHC反应种属: Human,Mouse,Rat
-
分类: 科研抗体货号: P43645别名: NFIA; KIAA1439; Nuclear factor 1 A-type; NF1-A; Nuclear factor 1/A; CCAAT-box-binding transcription factor; CTF; Nuclear factor I/A; NF-I/A; NFI-A; TGGCA-binding protein; NFIB; Nuclear factor 1 B-type; NF1-B; Nuclear factor 1/B; CCAAT-box-binding transcri应用: WB,IHC反应种属: Human,Mouse,Rat
-
分类: 科研抗体货号: P43613别名: Nucleolar protein 10应用: WB,IHC反应种属: Human,Mouse,Rat
-
分类: 科研抗体货号: P43628别名: Serine protease inhibitor Kazal-type 5; Lympho-epithelial Kazal-type-related inhibitor; LEKTI应用: WB,IHC反应种属: Human,Mouse
-
分类: 科研抗体货号: P43644别名: DUSP1; CL100; MKP1; PTPN10; VH1; Dual specificity protein phosphatase 1; Dual specificity protein phosphatase hVH1; Mitogen-activated protein kinase phosphatase 1; MAP kinase phosphatase 1; MKP-1; Protein-tyrosine phosphatase CL100; DUSP4; MKP2; VH2; Dual应用: WB,IHC反应种属: Human,Mouse,Rat

鄂公网安备42018502007531号
鄂公网安备42018502007531号

